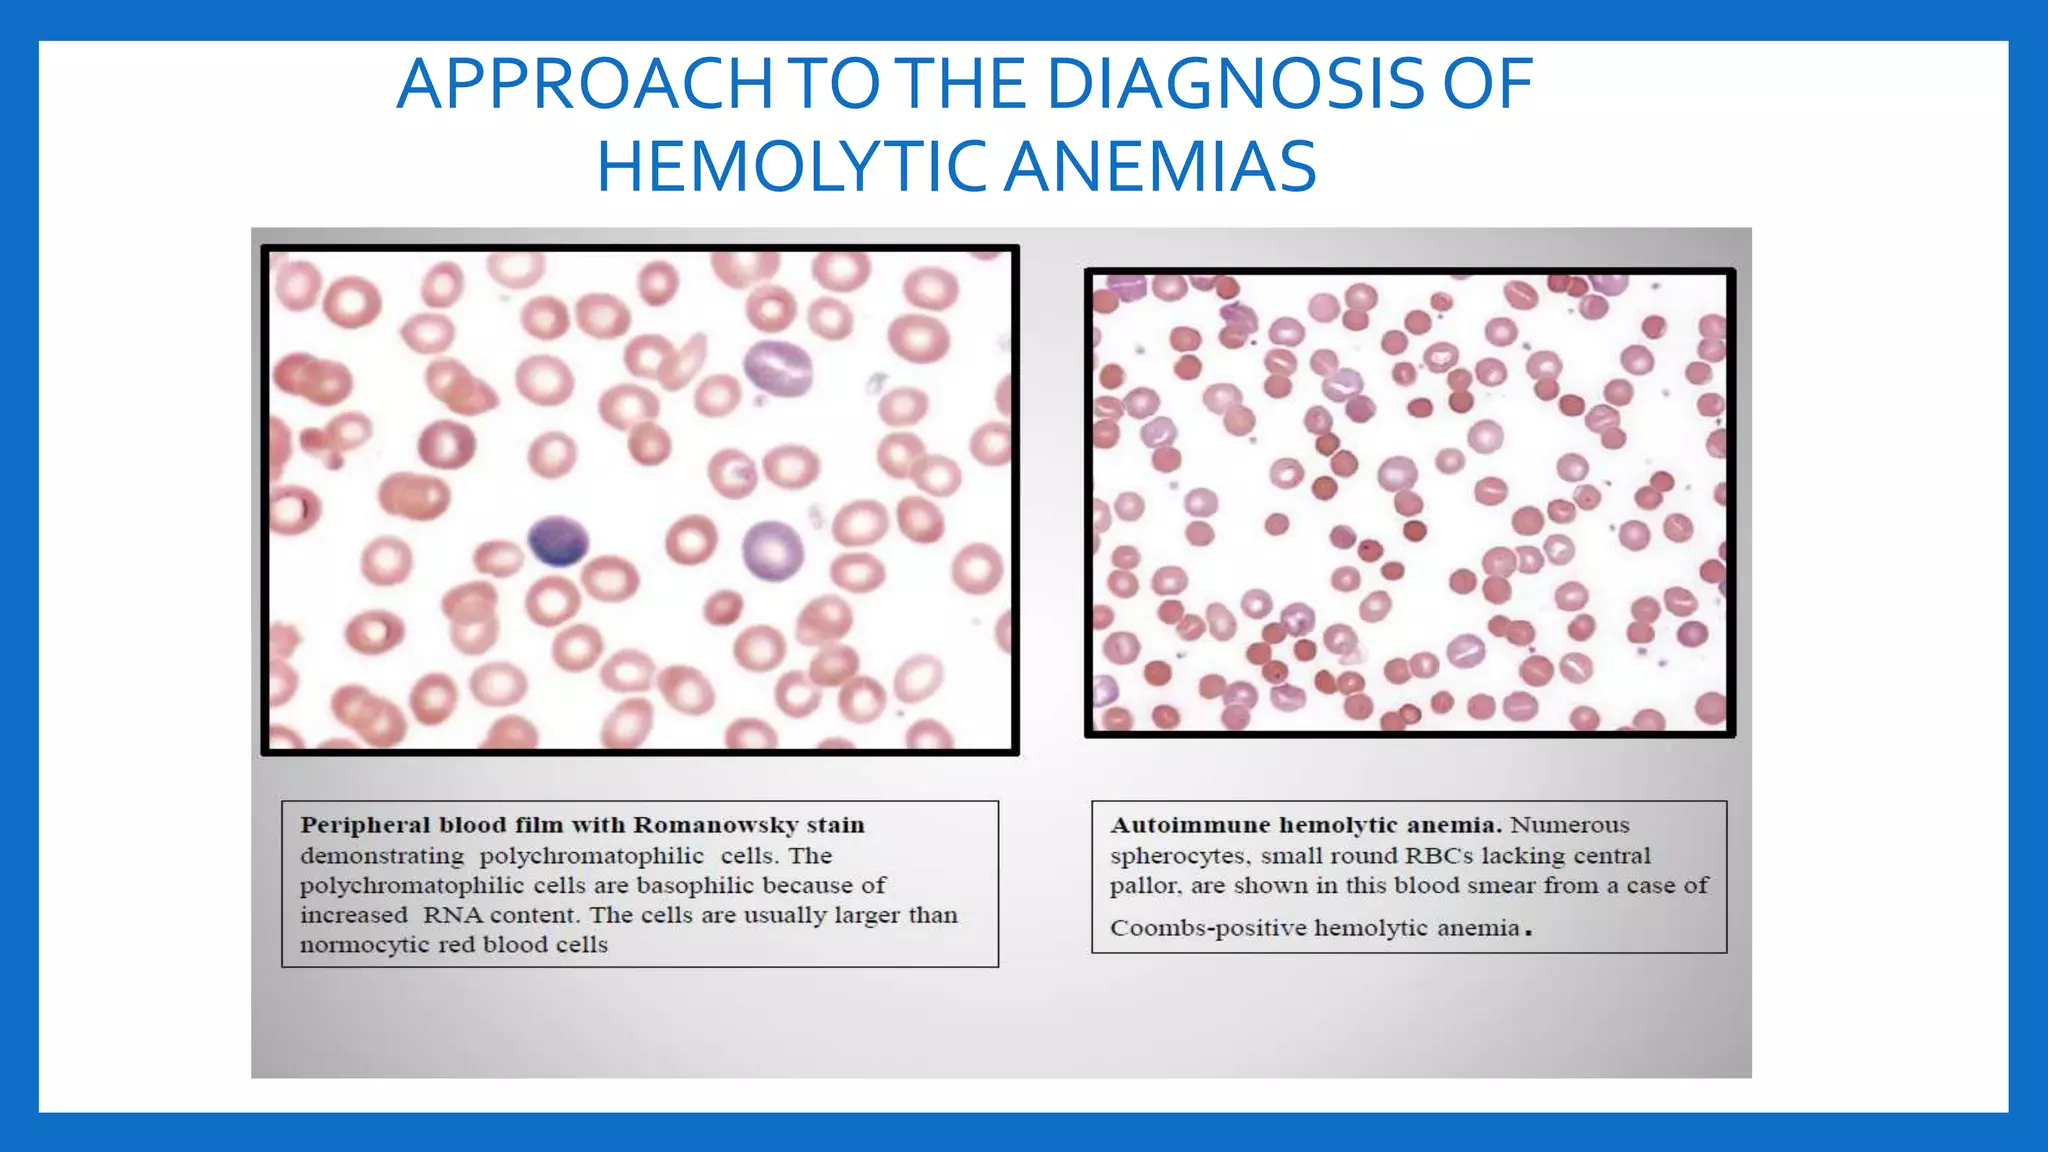
APPROACHTOTHE DIAGNOSIS OF
HEMOLYTIC ANEMIAS

Hemolytic anemias are characterized by the accelerated destruction of red blood cells. The document discusses the pathogenesis, clinical features, investigations, and approaches to diagnosis of various hemolytic anemias including hereditary spherocytosis, glucose-6-phosphate dehydrogenase deficiency, thalassemias, and sickle cell disorders. Key diagnostic tests involve peripheral blood smear, reticulocyte count, lactate dehydrogenase, and tests to identify the underlying genetic cause or enzyme deficiency.